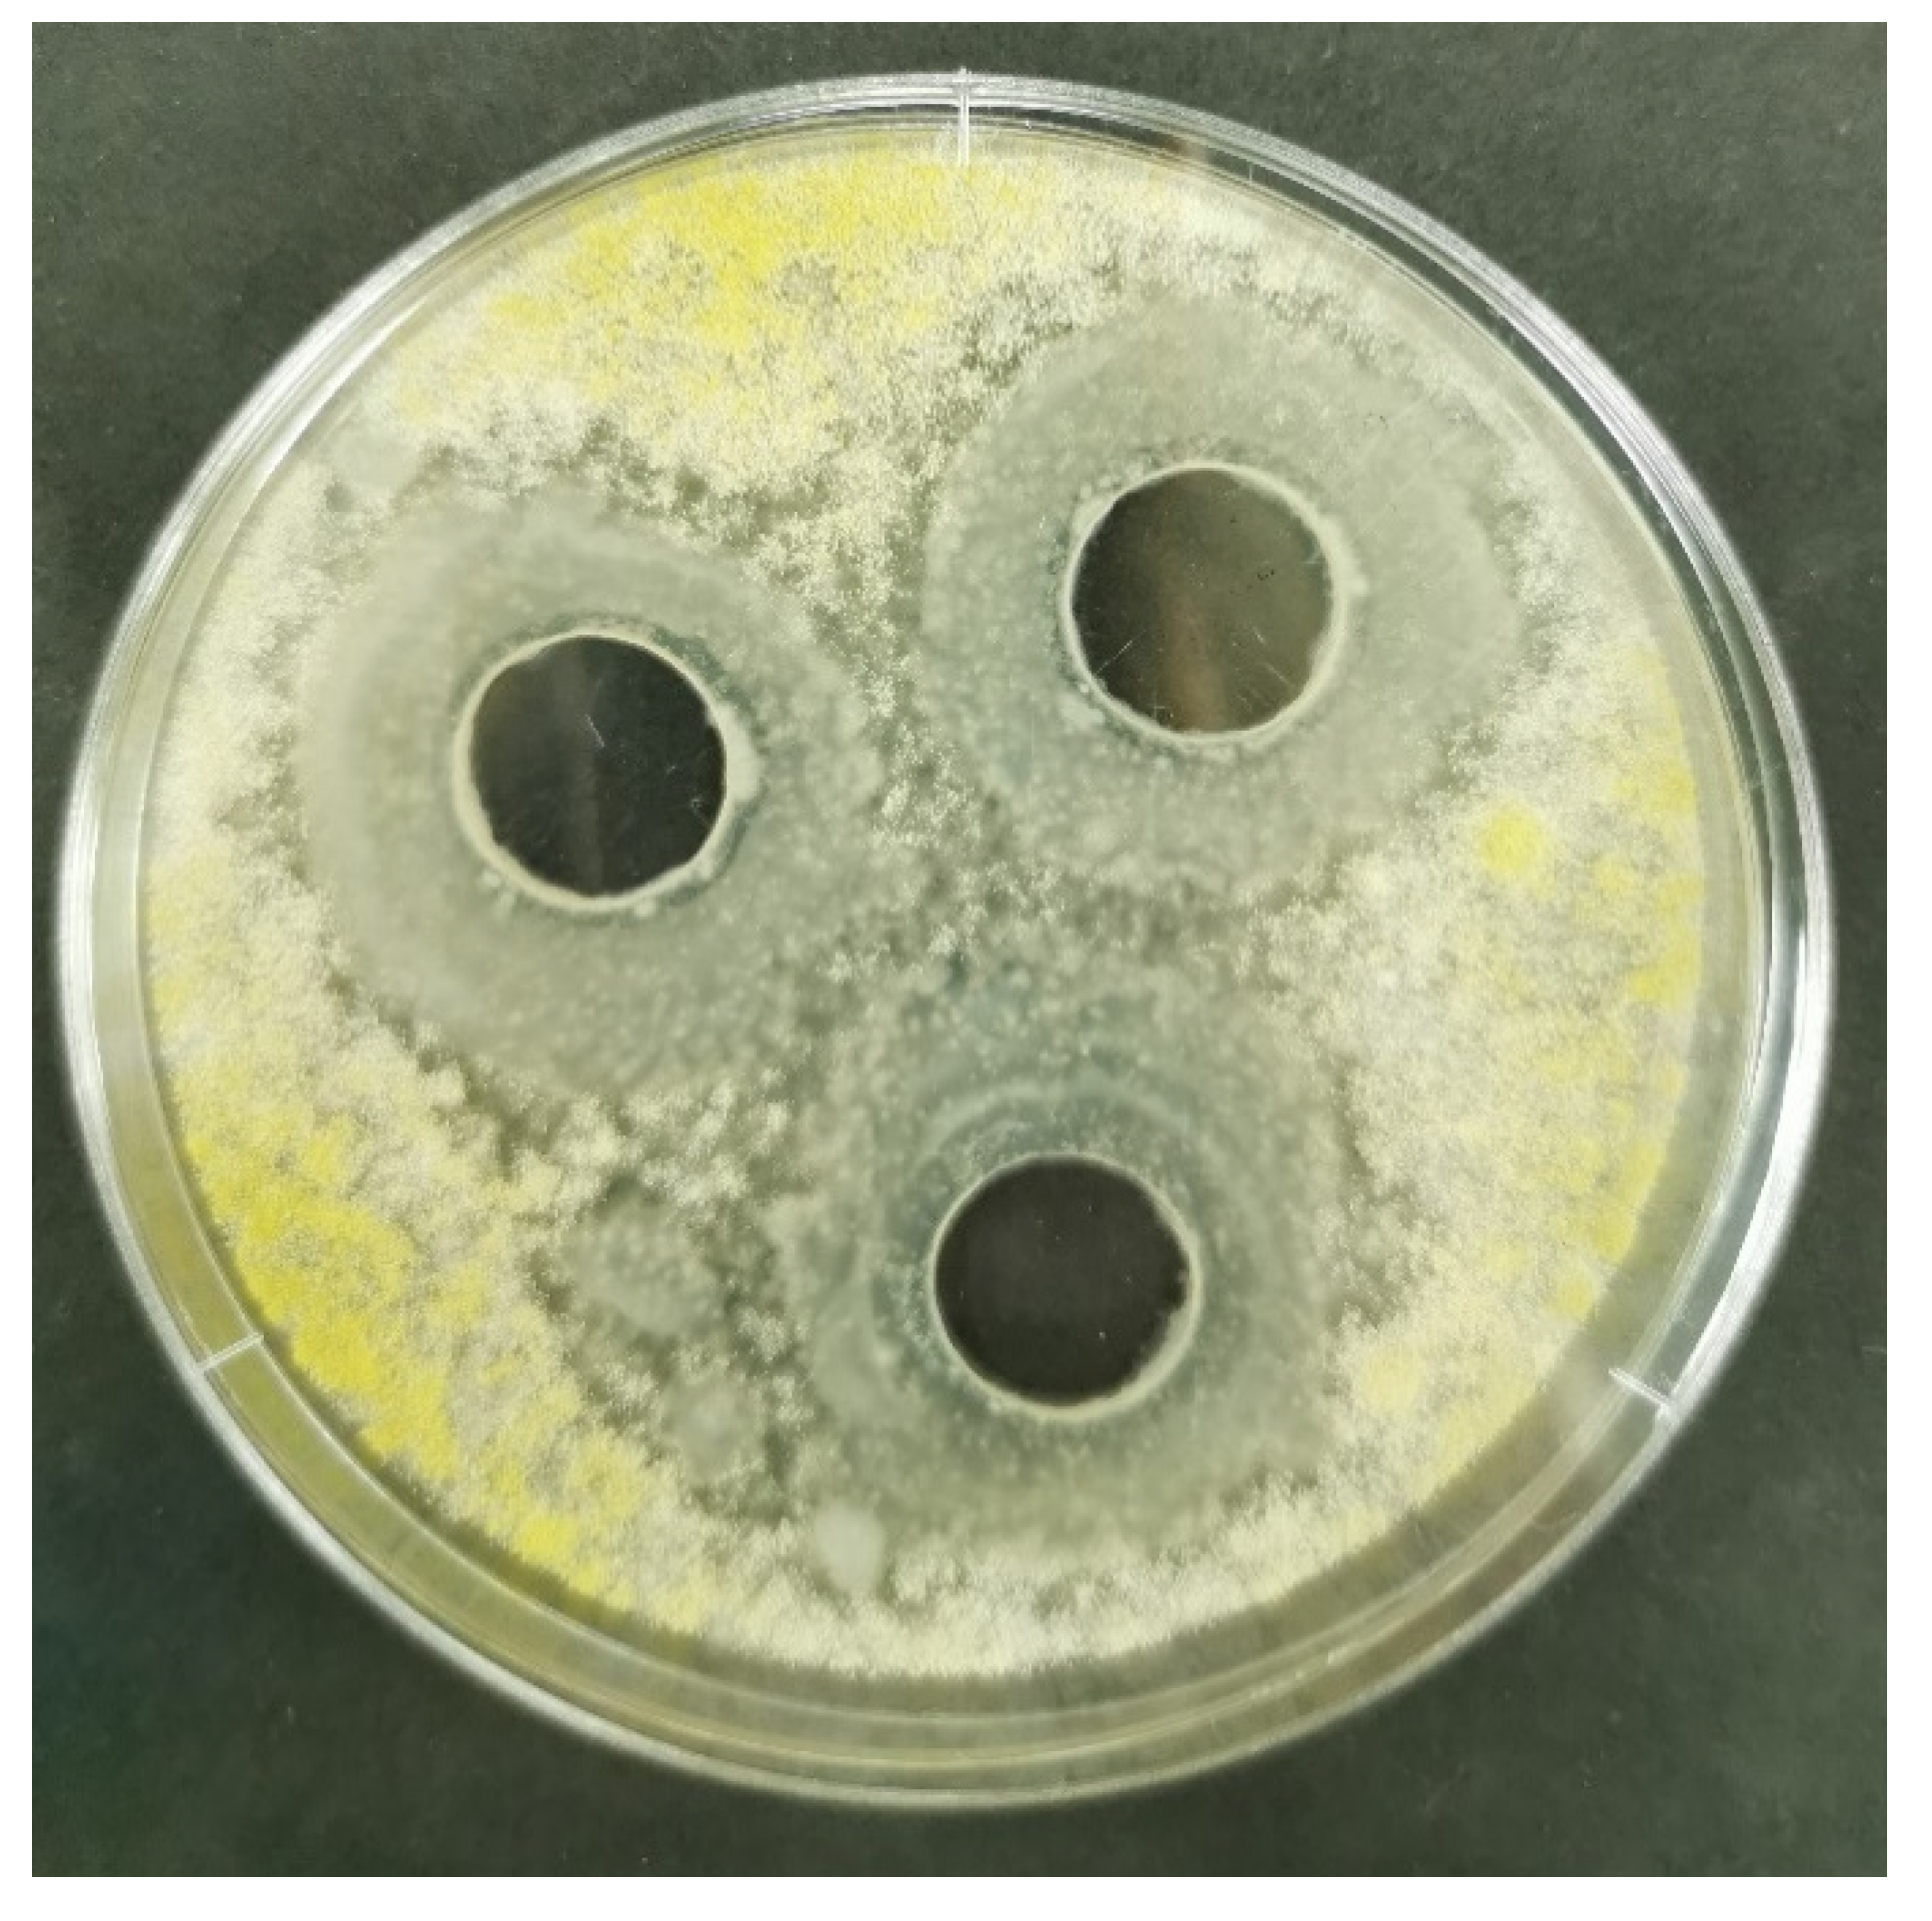
Toxins 13 00687 g002 550

1. Introduction
The share of agricultural production in the gross domestic product (GDP) in the Republic of Serbia accounts for approximately 10%. The country’s economic development heavily depends on the agricultural sector due to its importance in the food industry, where crops are used as raw materials, and the contribution of agricultural products in international trade. In 2020, maize was ranked second on the list of export products in the Republic of Serbia. It supports the fact that maize is the crop of strategic importance for the country [
1]. Speaking globally, there are three leading agricultural crops: wheat, rice, and maize [
2]. The maize taking the dominant position in the world agricultural system is explained by the possibility of being used in not only food but other industry branches as a multipurpose crop. High nutritional values (carbohydrates content 70–75%) make maize suitable raw material for food and feed production and define this crop as a critical factor for world nutrition and livelihood security [
3].
Numerous fungal plant diseases and their effect on the qualitative and quantitative aspects of food production led to significant economic losses measured in billions of US dollars worldwide [
4]. On the other hand, a limited number of fungal pathogens can cause severe problems affecting food safety and profitability of the plant production comparable to the negative impact caused by the
A. flavus species [
5,
6]. The estimation of the European Commission (EC) confirms the influence of mycotoxin contamination resulting in annual global crop losses of 5 to 10% [
7].
A. flavus is an opportunistic fungal pathogen of crops, predominantly maize, peanuts, and cotton, characterized by the high potential for aflatoxin production [
5]. Aflatoxins are potent, highly toxic secondary metabolites that can compromise food and feed security and cause severe health issues [
8]. Even exposure to low concentrations of aflatoxin increases the risk of immune suppression, malabsorption of nutrients, infertility, and reduction in life expectancy [
9,
10]. Aflatoxin class considers four major types, including B1, B2, G1, and G2, and from the food safety point of view, the most relevant is aflatoxin B1 (AFB1) [
11]. According to the International Agency for Research on Cancer (IARC) AFB1 is characterized as a carcinogen (Group 1a) [
11,
12].
The aflatoxigenic potential of
A. flavus varies from atoxigenic to highly toxigenic strains [
12]. The incidence of a toxigenic
A. flavus species has been shown to be associated with geographic origin and substrate characteristics [
13]. Previous studies on the distribution of
A. flavus in maize fields reported a high incidence of atoxigenic strains (above 70%) [
14]. The significance of
A. flavus as a plant pathogen lies in aflatoxin contamination, and less in resulting yield losses as a consequence of plant infection. Additionally, contamination levels and manifested infection symptoms are commonly disproportional. It means that even barely noticeable infection signs could be followed by high-level aflatoxin contamination [
11]. Regarding the distribution in the ecological niches,
A. flavus species are the most common habitants of the tropical environment, with a relatively high temperature range of 28 °C to 37 °C and high relative humidity of about 95% [
9]. Under the common climate conditions, the occurrence of the
A. flavus on the territory of the Republic of Serbia is not typical [
11]. However, global climate changes triggered the more frequent occurrence of the
A. flavus species in the regions generally characterized by the low risk of contamination [
15]. In the past decade, several aflatoxin outbreaks worldwide raised awareness about the importance of defining strategies effective in preventing the development of aflatoxigenic strains [
16]. As a consequence of the extremely drought 2012 producing season, the Republic of Serbia faced an aflatoxin outbreak in maize fields resulting in significant economic losses [
11].
The scientific community recognized the application of biocontrol agents as a promising sustainable solution to address the emerging issue [
17,
18]. Bacteria belonging to the
Bacillus genus are conceded as a plant beneficial species in agricultural practice due to high antagonistic activity against phytopathogenic organisms, the ability to promote plant growth, and improve the soil quality [
19]. The primary role as a biological tool for plant disease management is defined by the outstanding ability of the
Bacillus species to out-compete the target pathogens by the synergistic activity of antimicrobial compounds, competition for nutrient sources and space, and triggering induction of plant’s defense response [
20]. Besides antibiotics,
Bacillus strains are well known for the production of many other metabolites of interest, including biosurfactants and enzymes [
21]. Additional criteria making
Bacillus species ideal candidates for the application in biocontrol are spore-forming ability, rapid replication, and resistance to adverse environmental conditions [
22].
Numerous studies have proven the high potential of
Bacillus species in the suppression of fungal pathogens. Besides promising scientific results and high potential, the full commercialization of microbial biopesticides is still in the preliminary phase, with a limited number of products available on the market. The existing disbalance between the incontestable potential and the current market scenario requires constant research and efforts to isolate novel strains with high antagonistic activity. Estimating their antimicrobial potential and suitability to be used as a central point for designing viable bioprocess solutions is a necessary precondition for boosting the commercialization and broader use of microbial biopesticides [
23]. Development of the biotechnological solution for the production of biocontrol agents starts with selecting the strain expressing the highest potential in suppression of the target pathogen. The beginning of the screening procedure typically includes a significant number of potentials producing strains. The rhizosphere soil is a well-known source rich in antagonistic strains. Bacterial strains originating from the rhizosphere naturally coexist in the dynamic environment and constantly interfere with numerous microbial community members [
24]. The great advantage of
Bacillus strains as biocontrol agents is that they are core soil inhabitants, well adapted to the environmental conditions where they should be lately applied in the form of biopesticide [
21].
In the Republic of Serbia, an agricultural practice still relies on the usage of chemical pesticides. The biopesticides market in the country is still underdeveloped and accounts for only 1.3% of the overall market of plant protection products. Data on the biopesticides import in the period from 2015 to 2020 indicates that the largest amount of imported biopesticides refers to bioinsecticides, followed by biofungicides, bioacaricides, and biobactericides [
25,
26]. Currently, there is a limited number of microbial biopesticides registered and available on the Serbian market. To establish the basis for eco-friendly future in plant protection, co-operation between the scientific community, government, and private sector is needed [
23].
Since identification and quantification of aflatoxins in food sources are significant steps in food safety management [
8], the principal aim of this study was to evaluate the aflatoxigenic potential of
A. flavus species isolated from the maize originated from the different localities of the Republic of Serbia. Aflatoxin contamination of the maize samples harvested in 2019 and 2020 was evaluated by the HPLC and the ELISA method. The genetic potential of isolated
A. flavus species in terms of aflatoxin production capacity was examined by CAP analysis. The second aim was to find the effective biological response to the phytopathogenic fungi development by isolating and evaluating the potential of
Bacillus spp. strains to be used as biocontrol agents, against toxigenic
A. flavus strains. The novel strains were isolated from the rhizosphere soil of different vegetable plants, originated from localities in the Autonomous Province of Vojvodina, Republic of Serbia. The antagonistic effect of
Bacillus spp. against toxigenic and atoxigenic
A. flavus strains was determined by the well diffusion assay.
3. Discussion
The sampling of maize harvested in 2019 and 2020 was performed at 18 and 10 different localities in the Republic of Serbia, respectively. The samples were investigated for the presence of aflatoxin B1 using the ELISA test (
Table 3 and
Table 4), and the content of aflatoxin B1 and total aflatoxins content were determined using the HPLC method (
Table 1 and
Table 2). The results indicated only one sample with positive result originated from the territory of Loznica, whose total aflatoxin content was below the limit defined by the legislative in the Republic of Serbia (0.002 mg/kg), and the sample was considered as safe from the aspect of food safety. Therefore, based on the presented results, it could be concluded that these two growing seasons resulted in the production of aflatoxin-free or health-safe maize in the selected localities in the Republic of Serbia. In terms of weather conditions, both years were characterized as warm seasons with average annual precipitation rate, and heavy rains during May and June in 2019, and June of 2020 [
30,
31]. Described weather conditions are defined as convenient for undisturbed maize production and timely harvest [
32]. Previous studies indicated the weather conditions influence the incidence and level of aflatoxin contamination of maize grown in the Republic of Serbia. For instance, in the period from 2009–2011 occurrence of aflatoxins in maize samples was not detected [
33]. A significantly different scenario happened only a year later. Weather conditions changes, including hot and dry spring and summer in 2012, and drought period that lasted from June to September, resulted in heavy infections of maize by
A. flavus and, consequently, significant aflatoxin contamination [
34]. The contamination level of the maize samples was in the range from 1.01 to even 86.1 µg/kg [
33]. Similar weather conditions but with an absence of prolonged drought period occurred in growing season 2013. The occurrence of aflatoxins in maize this season indicated a lower contamination frequency of aflatoxins (24.7%) in comparison to 2012 (72.2%) [
35]. In contrast with the weather conditions in 2012 and 2013, in 2014 an extreme amount of precipitation was recorded. The increased moisture created unfavorable conditions for
A. flavus infections and resulted in absence of aflatoxins in maize samples. A year later, aflatoxin contamination was again recorded (36.5%), but in 2016 high precipitation rate limited growth of the aflatoxigenic fungi (5% of contaminated maize samples) [
35]. Vegetation season in 2017 was warmer and dryer above average weather conditions, and results of the analyses for the aflatoxin presence in maize samples collected in the Autonomous Province of Vojvodina, northern agricultural part of the Republic of Serbia, indicated a contamination level of 67% [
36].
Afterwards, isolation of potential aflatoxin producers was performed using the obtained maize samples from 2019 from 18 locations. The selective medium was used during isolation to target
A. flavus strains, which show the greatest potential to produce aflatoxins [
27]. Macromorphological (
Figure A1—
Appendix C) and micromorphological (
Figure A2—
Appendix D) characterization was applied to confirm the belonging of the isolated strains to the species
A. flavus. Despite originating from different localities, most strains have shown similarities in morphological traits, which correspond to the morphological characteristics specific for the
A. flavus species [
37,
38].
The aflatoxigenic potential of the isolated
A. flavus strains was confirmed by the CAP analyses, previously successfully applied to address the genetic potential for aflatoxins production [
15]. The results of CAP analyses have suggested the high distribution of the strains with the genetic potential to produce aflatoxins on the territory of the Republic of Serbia. The results pointed out that even 90% of the strains had a genetic basis for the aflatoxins synthesis, while only one strain isolated from maize sample from the locality Rogojevac (RO2B) had significant deletions in the aflatoxin biosynthesis gene cluster. The inability of this strain to produce aflatoxins is lately confirmed by the artificial inoculation of the maize seeds and the HPLC analyses to determine the content of the produced aflatoxins during artificial inoculation. Methods for monitoring indels within gene clusters required for the biosynthesis of aflatoxins and cyclopiazonic acid (CPA) are used for detecting intraspecies variability of
A. flavus, but also for the selection of isolates with atoxigenic properties as potential biocontrol agents [
28,
39,
40,
41]. Based on deletions and insertions of nucleotides in the sequence of an aflatoxigenic gene, a pattern that implicates stability of toxigenic properties is created. Therefore, cluster amplification pattern (CAP) analysis provides information about the stability of atoxigenic isolates [
28], but also for potential and stability in the synthesis of aflatoxins and CPA. The absence of deletions in both aflatoxin and CPA clusters may be a criterion for the selection of toxigenic isolates given that many authors stated additive or even synergistic effects of aflatoxins and CPA [
42,
43,
44]. The aim of this research was to determine the isolates’ capacity for aflatoxin biosynthesis, to select the most stable and potent isolate in aflatoxin production, and to test the efficacy of biocontrol agent based on
Bacillus spp. against primarily toxigenic isolates. Therefore, genes for aflatoxins and CPA were observed in the first place. Sugar cluster, adjacent to aflatoxin and CPA clusters was also monitored for deletions, however, according to available literature sources, the sugar gene cluster has no direct influence on aflatoxin biosynthesis or the expression on genes in the aflatoxin cluster. Nevertheless, there are data about the possible indirect relationship between these two clusters [
45]. Aflatoxin formation relies upon carbon source in a way that simple sugars (glucose, sucrose, fructose, and maltose) support aflatoxin synthesis, while peptone, sorbose, or lactose does not. Additionally, close proximity between the two gene clusters indicates a linkage between them in the metabolism of carbohydrates leading to the induction of aflatoxin biosynthesis. Further, the
nadA gene in the aflatoxin biosynthetic pathway was considered to be a part of the sugar cluster, however, gene profiling studies using microarray proved that this gene belongs to the aflatoxin gene cluster and has a role in AFG1/AFG2 formation [
45,
46].
Variations in profiles obtained by the CAP analysis indicate different toxigenic profiles that are in relation to the stability in the biosynthesis of aflatoxin in artificially inoculated samples. Isolates that expressed the highest potential for aflatoxin production (VA1BSS, SA2BSS, PA2DSS) and those with lower detected aflatoxin levels (LO1ASS, SO1ASS, SU1ASS, NA2BSS) have similar profiles. Also, a similar CAP profile in the aflatoxin cluster (AC01-AC13) have isolates with no aflatoxin detected in the maize sample (BČ1CSS, ŠT2BSS). This could be explained by the fact that the synthesis of aflatoxins depends on various factors that can modulate the expression of genes responsible for coding enzymes that control the biosynthesis pathway [
10]. These may also include environmental factors which may activate different cell signaling pathways that can affect the expression of the genes involved in toxin production. The inability of aflatoxin production is a result of deletions which are common for the genes involved in the early stages of aflatoxin biosynthesis. In contrast, genes responsible for the later stages are usually characterized by the presence of single nucleotide polymorphisms (SNPs) [
47]. Generated genetic profiles of the aflatoxin biosynthesis gene cluster indicated intraspecies variability between the aflatoxigenic strains, which could be classified into four groups. Genetic diversity among
A. flavus strains isolated from different localities could be explained by the difference in cropping practice employed in a certain field [
48]. Additional reasons are gene flow as a result of human activities as well as different competition strategies of
A. flavus strains depending on the environmental conditions [
48].
Climate conditions are critical factors for the growth and development of
A.flavus and subsequent aflatoxin biosynthesis [
15]. The 2019 and 2020 seasons in the Republic of Serbia were similar and unfavorable for the development of the
A. flavus in terms of weather conditions. The results of this study confirmed the lack of maize contamination, except for one sample (from the locality Loznica from 2019), but with the aflatoxin content below the permissible limit. However, proven genetic potential and confirmed gene expression resulting in the high amount of produced AFB1 and total aflatoxins after artificial inoculation of maize seeds have demonstrated the remarkable capacity of the
A. flavus strains present in the fields of the Republic of Serbia to produce aflatoxins. Favorable climate conditions, drought, and heat stress increase the probability of
A. flavus development and pose a risk for a high level of aflatoxin contamination in maize as an entry point of a food chain. This kind of scenario combined with unpredictable consequences of climate changes implies the necessity of strict control of
A. flavus distribution in the fields. Considering the maize as a crop of strategic importance in the Republic of Serbia, the consequences of the potential damage due to the outbreak of aflatoxin contamination would dramatically influence the country’s economy and food and feed safety, as previously seen in season 2012 [
49]. If climate conditions changes initiate more regular aflatoxin contamination in the United States of America, as the largest maize producer, it was estimated that losses to the maize industry could reach from
$52.1 million to
$1.86 billion annually [
50]. Therefore, this study was also focused on the investigation of sustainable biocontrol methods for suppression of
A. flavus, as a means of preventive action for aflatoxin contamination emergence. On the other hand, the production of aflatoxins brings the more severe consequence of
A. flavus presence in the maize fields, but what also should be taken into account are economic losses due to maize fungal infection. Fungal diseases of cereals can cause a yield reduction in the range from 15–20%, but even more in some extreme cases (60%) [
51].
Screening of the bacteria belonging to the
Bacillus genus as a promising biocontrol agent revealed intensive suppressive activity exhibited by the Mah 1a and Mah 1b strains against toxigenic and atoxigenic
A. flavus strains, isolated from the maize grown in the Republic of Serbia. The preliminary screening included 76
Bacillus strains as potential antagonists against one aflatoxigenic
A. flavus (SA2BSS) strain, with the highest potential of aflatoxin B1 production. On the other hand, the main screening experiment included all isolated
A. flavus strains to evaluate if there is a difference in the activity of
Bacillus strains on
A. flavus population. Both antagonistic strains characterized by the highest inhibitory activity (Mah1a and Mah1b) were isolated from the rhizosphere soil of the
Phaseolus vulgaris. Additionally, antagonistic and phytopathogenic strains originate from the same region, which contributes to the efficiency and adaptation capability of selected biocontrol agents to the environmental conditions of the potential application site [
21]. The rhizosphere is a great source of beneficial bacterial strains, and almost 95% of the soil Gram-positive bacilli are a member of the
Bacillus genus [
52]. The
Bacillus strains isolated from the rhizosphere soil of the
Phaseolus vulgaris were previously defined as strains of agricultural interest due to their plant-beneficial and pathogen-suppressing activities [
22,
53,
54]. Production of extracellular enzymes is of great importance since it contributes to biocontrol activity and adaptation to the environmental conditions, giving those strains a more competitive advantage over the other microbial inhabitants of the particular ecosystem [
52]. The
Bacillus strains are marked out as core members of the microbiome in
Phaseolus vulgaris rhizosphere [
55]. Moreover,
Bacillus spp. Isolated from the
Phaseolus vulgaris rhizosphere stood out by their superiority among other strains thanks to their plant growth promotion characteristics and potential for antimicrobial metabolites production [
56]. Hence, the isolated
Bacillus strains Mah 1a and Mah 1b successfully inhibited the growth and development of
A. flavus in vitro. These strains are currently being further investigated as potential biocontrol agents for the suppression of fungal maize diseases and aflatoxin contamination. Previous studies also indicated the use of
Bacillus spp. For the suppression of fungal pathogens [
57,
58,
59,
60], including
Aspergillus species [
18,
61,
62,
63]. Further research from the aspect of biocontrol product development should first include identifying the selected antagonists and the precise determination of the mechanism of antifungal activity. Depending on the previously defined mechanism of action, further steps in bioprocess development should be determined to achieve the maximization of microbial biomass or metabolites production. Development of the bioprocess solution should include optimization of the medium composition, bioprocess parameters, and downstream procedure for the production of the microbial biocontrol agent. The initial investigation steps should be performed at the laboratory scale with the perspective of scaling up the developed production technology to pilot or industrial level [
21,
64,
65]. All these phases should be followed by
in planta testing under field conditions to obtain a highly efficient biocontrol product for suppression of
A. flavus and an eco-friendly tool for preventive action against aflatoxin contamination outbreaks.